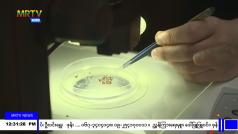

- Home
- News
- Live Stream
- Radio
- Schedule
- Program
-
Information
- About MRTV
- PMS Rules & Regulations
- Advertisement Rate
- Relay Stations
- Code of Ethic
- Broadcasting Law
- Broadcasting Law (Amendment No. 19) (21-6-2018)
- Broadcasting Law (Rules and Regulations)
- MRTV Broadcasting Guidelines
- Mpedia- Knowledge Book for MRTV News Reporting
- Fundamental Code of Broadcasting Ethics and Code of Conduct
- E-Services